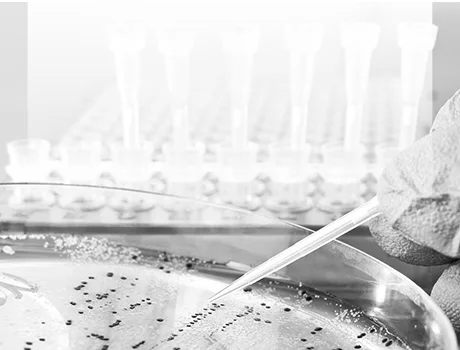

Overcoming Challenges in International Import of Medical Implants
The international import of medical implants can present various challenges for companies seeking to enter the Latin American markets. The medical device distribution industry in the region is characterized by fragmentation, with numerous small distribution companies operating independently. From supply chain complexities to import duties and cultural differences, navigating these obstacles requires careful planning and strategic solutions. In this blog, we will address common challenges faced by medical implant companies during the import process and provide actionable solutions to overcome them in the Latin American context.
Supply Chain Complexities
The complex nature of the medical implant supply chain, including multiple stakeholders and regulatory requirements, can lead to delays and logistical challenges. The main disruption for Latin American traders comes from increased shipping costs and long delays to products arriving at their destinations, considering that the US and China, which are significantly affected by bottlenecks at ports, are their main export markets.
Also, finding a reliable and high-quality distributor in Latin American countries can be a significant challenge when entering the market with your medical device. To overcome this, establish partnerships and build strong relations with local distributors or agents who possess expertise in the Latin American market. Their knowledge of local regulations, customs processes, and distribution networks can help streamline the supply chain.As international device companies seek to expand their market reach, they rely on distributors to not only handle logistics but also play a strategic role in pricing, positioning, and marketing their devices. The success or failure of your device in Latin America can heavily depend on the capabilities and performance of your chosen distributor.
If feasible, set up regional distribution centers strategically located within Latin America to reduce lead times, optimize inventory levels, and enhance responsiveness to customer demands. Implementing robust track-and-trace systems to ensure visibility and traceability throughout the supply chain enables efficient inventory management and improves the accuracy of order fulfillment.
Import Duties & Tariffs
Import duties and tariffs imposed by different countries can significantly impact the cost competitiveness of medical implants. The challenges posed by import duties and tariffs in Latin American countries revolve around increased costs, reduced competitiveness, market access barriers, and administrative complexities. To overcome this, Investigate existing trade agreements or preferential tariffs between your country of origin and the target Latin American markets. Utilize these agreements to minimize import duties and reduce costs.
Explore duty exemption programs offered by local governments or regulatory bodies for medical devices. By meeting specific criteria, companies may qualify for reduced or exempted import duties. Also, we could consider localizing certain aspects of the supply chain, such as manufacturing or assembly, within the target markets. This can help mitigate import duties and enhance cost-effectiveness.
Cultural Differences and Language Barriers
Cultural differences and language barriers can hinder effective communication, collaboration, and understanding between medical implant companies and local stakeholders. To overcome this engage local representatives or hire bilingual staff who are familiar with the target market’s culture, language, and business practices. This facilitates smoother communication and relationship-building with regulatory authorities, suppliers, and healthcare providers. Invest time and effort to understand and appreciate the cultural nuances of the Latin American markets. Adapt business practices, marketing materials, and communication styles accordingly to establish trust and build strong relationships. Ensure that all product documentation, including user manuals, labels, and packaging, are accurately translated into the local language. Localization of marketing materials can also help resonate with the target audience and improve market penetration.
Regulatory Compliance
Navigating complex and evolving regulatory frameworks in different Latin American countries can be challenging and time-consuming. To overcome this, seek guidance from local regulatory experts or consultants who possess in-depth knowledge of the medical device regulations in the target markets. They can help navigate the registration process, ensure compliance, and expedite approvals, also advocate for regulatory harmonization across Latin American countries, supporting initiatives that aim to align standards and streamline the registration process for medical implants. Collaborate with industry associations and regulatory bodies to drive these efforts. In addition to that, proactively engage with regulatory authorities, attending conferences, workshops, and industry events. Building relationships with key stakeholders can help companies stay up-to-date with regulatory changes and provide opportunities to influence policy discussions.
Overcoming the challenges faced during the international import of medical implants in Latin American markets requires proactive planning, strategic partnerships, and adaptability. Latin America holds great potential for medical device companies from the USA, Europe, and other regions looking to expand globally. The industry in Latin America is strong, and the projected growth further adds to its appeal. However, it’s important to acknowledge that the region poses its own set of challenges. The regulatory environment varies between countries, and while trade unions like MERCOSUR provide some level of regulatory continuity, individual countries may still have their own specific requirements and processes. It is crucial to carefully assess and adapt your import strategies to maintain cost-effectiveness and maximize market potential.
